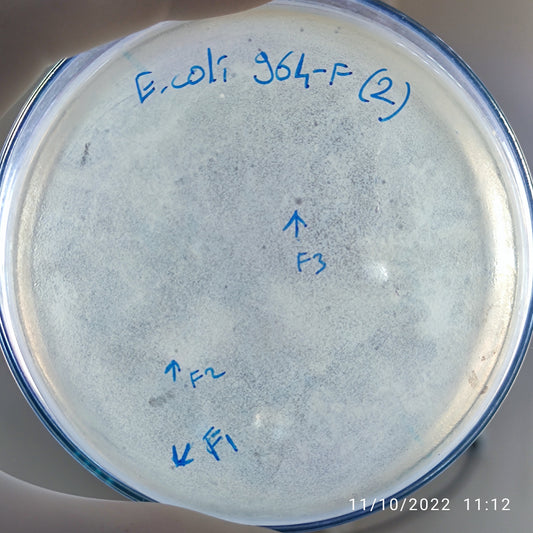
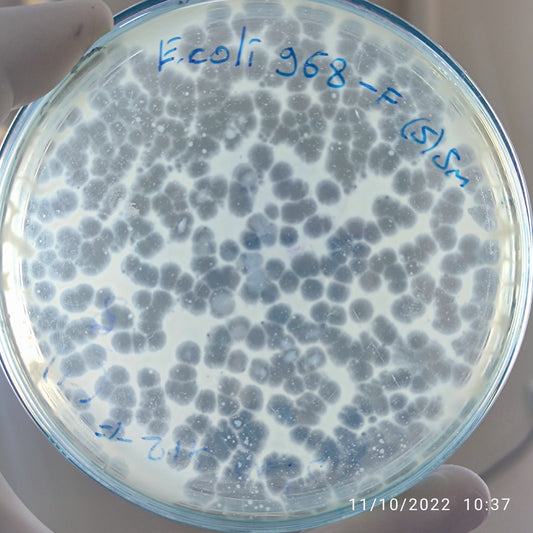
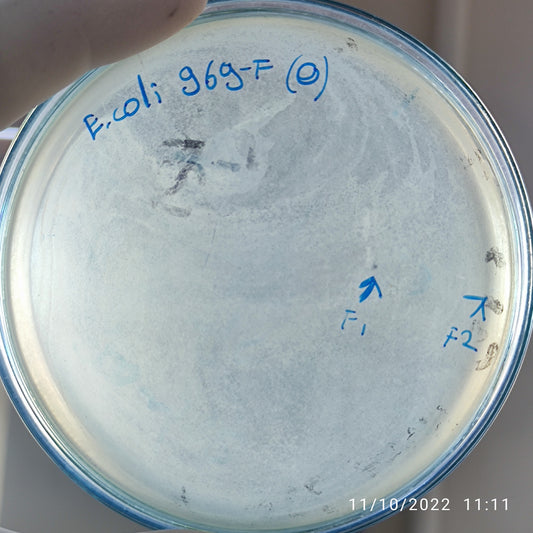
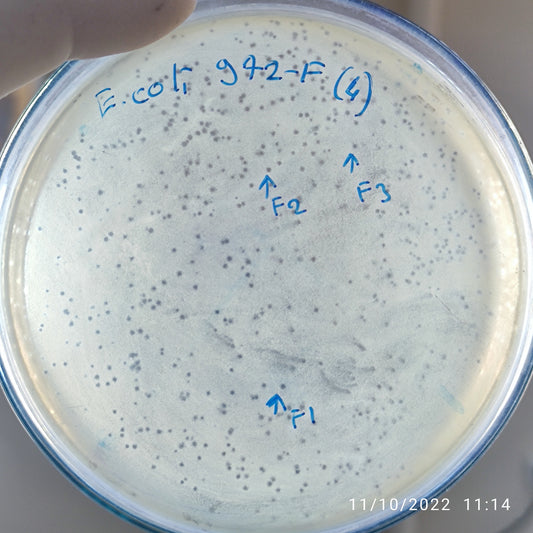
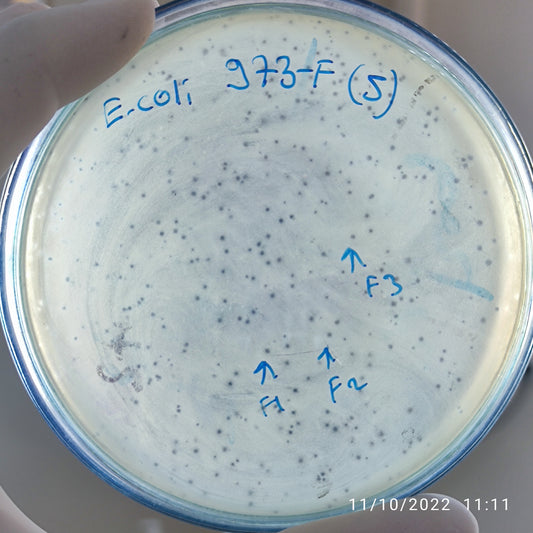
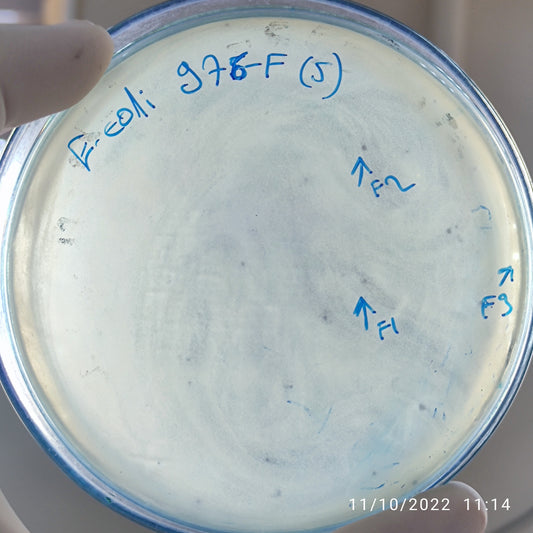
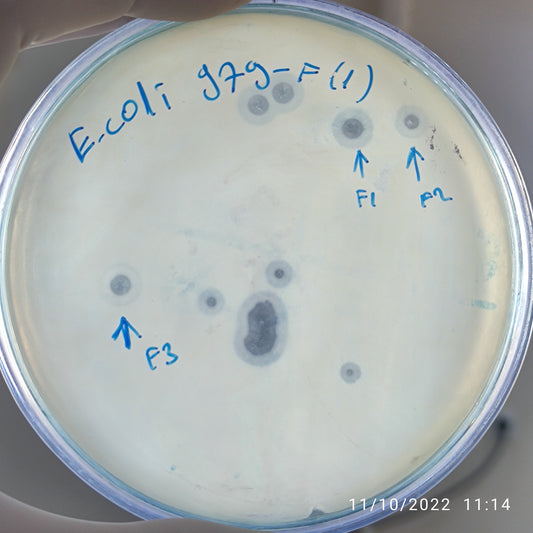
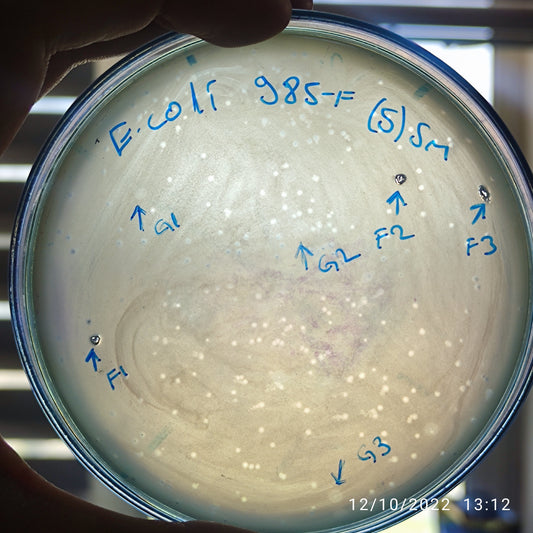

-
Escherichia coli bacteriophage 100964F
Regular price $500.00 USDRegular priceUnit price per -
Escherichia coli bacteriophage 100968F
Regular price $900.00 USDRegular priceUnit price per -
Escherichia coli bacteriophage 100969F
Regular price $500.00 USDRegular priceUnit price per -
Escherichia coli bacteriophage 100972F
Regular price $600.00 USDRegular priceUnit price per -
Escherichia coli bacteriophage 100973F
Regular price $750.00 USDRegular priceUnit price per -
Escherichia coli bacteriophage 100976F
Regular price $750.00 USDRegular priceUnit price per -
Escherichia coli bacteriophage 100977F
Regular price $600.00 USDRegular priceUnit price per -
Escherichia coli bacteriophage 100979F
Regular price $800.00 USDRegular priceUnit price per -
Escherichia coli bacteriophage 100980F
Regular price $500.00 USDRegular priceUnit price per -
Escherichia coli bacteriophage 100981F
Regular price $500.00 USDRegular priceUnit price per -
Escherichia coli bacteriophage 100982F
Regular price $500.00 USDRegular priceUnit price per -
Escherichia coli bacteriophage 100982G
Regular price $500.00 USDRegular priceUnit price per -
Escherichia coli bacteriophage 100983F
Regular price $500.00 USDRegular priceUnit price per -
Escherichia coli bacteriophage 100985F
Regular price $600.00 USDRegular priceUnit price per -
Escherichia coli bacteriophage 100985G
Regular price $500.00 USDRegular priceUnit price per -
Escherichia coli bacteriophage 100986F
Regular price $650.00 USDRegular priceUnit price per